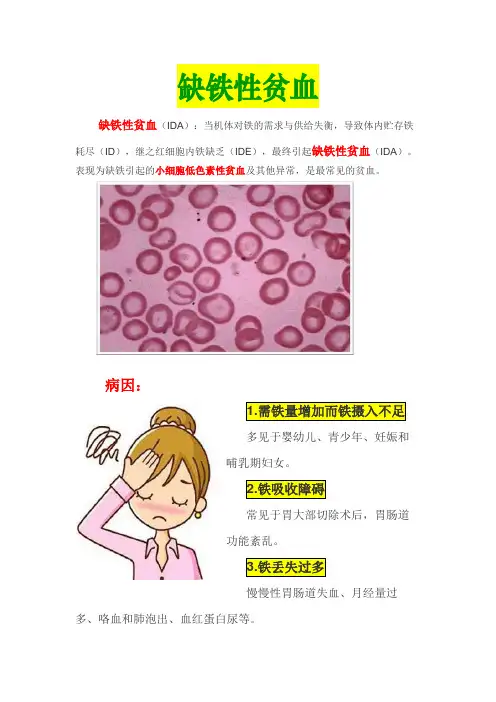

缺铁性贫血的缩写
- 格式:docx
- 大小:13.81 KB
- 文档页数:6
缺铁性贫血缺铁性贫血(IDA):当机体对铁的需求与供给失衡,导致体内贮存铁耗尽(ID),继之红细胞内铁缺乏(IDE),最终引起缺铁性贫血(IDA)。
表现为缺铁引起的小细胞低色素性贫血及其他异常,是最常见的贫血。
病因:1.需铁量增加而铁摄入不足多见于婴幼儿、青少年、妊娠和哺乳期妇女。
2.铁吸收障碍常见于胃大部切除术后,胃肠道功能紊乱。
3.铁丢失过多慢慢性胃肠道失血、月经量过多、咯血和肺泡出、血红蛋白尿等。
临床表现:1.缺铁原发病表现如妇女月经量多、消化道溃疡/肿瘤/痔疮导致的黑便/血便/腹部不适、肠道寄生虫感染导致的腹痛/大便性状改变、肿瘤性疾病的消瘦、血红蛋白尿等。
2.贫血表现乏力、易倦、头晕、头痛、眼花、耳鸣、心悸、气短、纳差、苍白、心率增快。
3.组织缺铁表现精神行为异常,如烦躁、易怒、注意力不集中、异食癖;体力、耐力下降;易感染;儿童生长发育迟缓、智力低下;口腔炎、舌炎、舌乳头萎缩、口角皲裂、吞咽困难;毛发干枯、脱落;皮肤干燥、皱缩;指(趾)甲缺乏光泽、脆薄易裂,重者指(趾)甲变平,甚至凹下呈勺状(反甲)。
治疗原则:①根治病因;②补足贮铁。
婴幼儿、青少年和妊娠妇女营养不足引起的IDA,应改善饮食。
补铁治疗:预防:重点放在婴幼儿、青少年和妇女的营养保健,对月经期妇女应防治月经过多,做好肿瘤性疾病和慢性出血性疾病的人群防治。
【健康宣教】1、积极配合医生寻找和去除病因,轻度贫血限制活动,重度贫血卧床休息,良好的休息,放松的心情及适量的运动,有利于增强身体的免疫力,增强体力和造血功能。
2、向病人及家属讲解平衡膳食对避免引发缺铁性贫血的重要性,生活中应注意纠正偏食习惯,要做到膳食要平衡,营养合理、而且机体的蛋白质供给要丰富,在日常生活中多吃含铁较多的食物为好,多吃一些紫菜、木耳,动物肝脏等。
3、对易患人群的预防教育:婴幼儿强调改进喂养方法,应及时增加辅食,如蛋黄、青菜、瘦肉和肝等合铁丰富食品,妊娠期、哺乳期妇女除食用含铁多的食物外,还可每日服少量硫酸亚铁0.2g。

血液系统疾病名称英文缩写AA:再生障碍性贫血(aplastic anemia)ACD:慢性病贫血(anemia of chronic disorders)aCML:不典型慢性粒细胞白血病(atypical chronic myeloid leukemia) AHA:自身免疫性溶血性贫血(autoimmune hemolytic anemia)AIHA:自身免疫性溶血性贫血(autoimmune hemolytic anemia)AL:急性白血病(acute leukemia)ALL:急性淋巴细胞性白血病(Acute lymphocytic leukemia)AML:急性粒细胞性白血病(Acute myelocytic leukemia)AMKL:急性巨核细胞白血病(acute megakaryocytic leukemia )ANLL:急性非淋巴细胞性白血病(acute nonlymphocytic leukemia ) APA:急性失血性贫血(acute posthemorrhagic anemia)ATL:成人T细胞白血病/淋巴瘤(adult t-cell leukemia/lymphoma) ATP:自身免疫性血小板减少性紫癜(autoimmune thrombocytopenic purpura)BL:嗜碱性粒细胞白血病(basophilic leukemia)CDA:纯红细胞再生障碍性贫血(congenital dyserythropoietic anemia) CEL:慢性嗜酸性粒细胞白血病(chronic eosinophilic leukemia) CIMF:慢性特发性骨髓纤维化(chronic idiopathic myelofibrosis) CL:慢性白血病(chronic leukemia)CLL:慢性淋巴系白血病(chronic lymphoid leukemia)CLL:慢性淋巴细胞白血病(chronic lymphocytic leukemia)CLPD:慢性淋巴细胞增殖性疾病(chronic lymphoproliferative disorders)CML:慢性髓系白血病(chronic myeloid leukemia)CML:慢性髓细胞白血病(chronic myelocytic leukemia)CML:慢性粒细胞白血病(chronic myelocytic leukemia)CMML:慢性粒-单核细胞白血病(chronic myelomonocytic leukemia) CMPDs:慢性骨髓增殖性疾病(chronic myeloproliferative disorders) CNL:慢性中性粒细胞白血病(chronic neutrophilic leukemia) DIHA:药物性溶血性贫血(drug-induced hemolytic anemia)EL:嗜酸性粒细胞白血病(eosinophilic leukemia)HA:溶血性贫血(hemolytic anemia)HAL:低增生性急性白血病(hypoplastic acute leukemia)HCL:毛细胞白血病(hairy cell leukemia)HSP:过敏性紫癜又称亨-舒综合症〔Henoch-Schonlein purpura〕IDA:缺铁性贫血(iron deficiency anemia)IM:传染性单核细胞增多症(Infectious Mononucleosis)IMF:原发性骨髓纤维化症(Idiopathic myelofibrosis)ITP:特发性血小板减少性紫癜(idiopathic thrombocytopenic purpura) JMML:幼年型粒-单核细胞白血病(juvenile myelomonocytic leukemia) LGLL:大颗粒淋巴细胞白血病(large granular lymphocytic leukemia) MA:地中海贫血(Mediterranean anemia)MA:巨幼细胞性贫血(megaloblastic anemia)MAL:急性混合细胞白血病(mixed acute leukemia)MCL:组织嗜碱细胞(肥大细胞)性白血病(mast call leukemia)MDS:骨髓增生异常综合征(myelodysplastic syndrome)MH:恶性组织细胞病(malignant histiocytosis)MH:恶性组织细胞增多症(malignant histiocytosis)ML:巨核细胞白血病(megakaryoblastic leukemia)MM:多发性骨髓瘤(multiple myeloma)PHT:原发性出血性血小板增多症(primary hemorrhagic thrombocythemia) PLL:幼淋巴细胞白血病(prolymphocytic leukemia)PNH:阵发性睡眠性血红蛋白尿(paroxysmal nocturnal hemoglobinuria) PRCA:纯红细胞再生障碍性贫血(pure red cell aplasia)PS:单纯性紫癜(purpura simplex)PT:原发性或特发性血小板增多症(primary or idiopathic thrombocythemia)PV:真性红细胞增多症(polycythemia vera)RA:难治性贫血(refractory anemia)RARS:难治性贫血伴环状铁粒幼细胞RAWS:难治性贫血伴铁粒幼红细胞增多(refractory anemia with sideroblastosis)RCMD:难治性血细胞减少伴有多系发育异常RCMD-RS:难治性血细胞减少伴有多系发育异常和环状铁粒幼细胞SA:铁粒幼细胞改贫血(sideroblastic anemia)SCVL:绒毛淋巴细胞脾淋巴瘤(splenic lymphoma with circulating villous lymphocytes)ST:继发性或反响性血小板增多症(secondary thrombocythemia)TEG:嗜酸性粒细胞增多症(cal eosinophilic granulocytosis)TTP:血栓性血小板减少性紫癜(thrombotic thrombocytopenic purpura)。


缺铁性贫血的缩写【篇一:缺铁性贫血的缩写】【疾病名】缺铁性贫血【英文名】iron deficiency anemia 【缩写】【别名】【icd 号】d50 【概述】缺铁性贫血(iron-deficiency anemia ,ida)是指由于体内贮存铁消耗殆尽、不能满足正常红细胞生成的需要而发生的贫血。
在红细胞的产生受到限制之前,体内的铁贮存已耗尽,此时称为缺铁。
缺铁性贫血的特点是骨髓及其他组织中缺乏可染铁,血清铁蛋白及转铁蛋白饱和度均降低,呈现小细胞低色素性贫血。
【流行病学】缺铁性贫血在生育年龄的妇女和婴幼儿中发病较多。
据who 1985 年报道,全球约30%的人患有贫血,其中至少半数(即约5~6 亿)为缺铁性贫血。
在大多数发展中国家里约有2/3 的儿童和育龄妇女缺铁,其中1/3 为缺铁性贫血。
在发达国家亦有20%的育龄妇女及40%左右的妊娠妇女患缺铁性贫血。
北京协和医院于1986~1990 年对河北、陕西、广东三省1851 岁以下儿童的调查发现缺铁及缺铁性贫血的发生率分别为49.0%和15.3%。
【病因】人体内的铁是呈封闭式循环的。
正常情况下,铁的吸收和排泄保持着动态的平衡,人体一般不会缺铁,只在需要增加、铁的摄入不足及慢性失血等情况下造成长期铁的负平衡才致缺铁。
造成缺铁的病因可分为铁摄入不足和丢失过多两大类(表1)。
1.铁摄入不足最常见的原因是食物中铁的含量不足、偏食或吸收不良。
食物中的血红素铁容易被吸收,且不受食物组成及胃酸的影响。
非血红素铁则需要先变成fe 才能被吸收。
蔬菜、谷类、茶叶中的磷酸盐、植酸、丹宁酸等可影响铁的吸收。
成年人每天铁的需要量约为1~2mg。
男性1mg/d 即够,生育年龄的妇女及生长发育的青少年铁的需要增多,应为1.5~2mg/d。
如膳食中铁含量丰富而体内贮存铁量充足,一般极少会发生缺铁。
造成铁摄入不足的其他原因是药物或胃肠疾患影响了铁的吸收,某些金属如镓、镁的摄入,制酸剂中的碳酸钙和硫酸镁,溃疡病时服用的h 抑制剂等,均可抑制铁的吸收。






常见血液病英文简写互联网 2007年11月29日1、 IDA 缺铁性贫血2、 MegA 巨幼细胞性贫血3、 HA 溶血性贫血4、 AA 再生障碍性贫血5、 AAA 急性再生障碍性贫血6、 CAA 慢性再生障碍性贫血7、 PRCA 纯红细胞再生障碍性贫血8、 SA 继发性贫血9、 SBA 铁粒幼细胞性贫血10、RA 难治性贫血11、RAEB 原始细胞增多性难治性贫血12、RAEB-t 转变中原始细胞增多性难治性贫血13、PA 恶性贫血14、IA 感染性贫血15、SCA 镰状红细胞贫血16、HS 遗传性球形红细胞增多症17、HE 遗传性椭圆形红细胞增多症18、HST 遗传性口形红细胞增多症19、PNH 阵发性睡眠性血红蛋白尿症20、AL 急性白血病21、ALL 急性淋巴细胞性白血病22、ANLL 急性非淋巴细胞性白血病23、AML 急性髓细胞性白血病24、AGL 急性粒细胞性白血病25、AmoL 急性单核细胞性白血病26、AmmL 急性粒-单核细胞性白血病27、AmgKL(AmKBL) 急性巨核细胞性白血病28、APL 急性早幼粒细胞性白血病29、AEL 急性红白血病30、CML 慢性髓细胞性白血病(慢粒)31、CGL慢性单核细胞性白血病32、CmmL 慢性粒-单核细胞性白血病33、CLL 慢性淋巴细胞性白血病34、CmL-BC 慢性粒细胞性白血病急性变35、PCL 浆细胞白血病36、PLL 幼淋巴细胞性白血病37、MAL 混合性白血病38、HAL 低增生性白血病39、HCL 毛细胞白血病40、ATL 成人T细胞白血病41、CNSL 中枢神经系统白血病42、G-ALL 颗粒性急性淋巴细胞白血病43、H-ALL 手镜形急性淋巴细胞白血病44、T-ALL T细胞急性淋巴细胞白血病45、B-ALL B细胞急性淋巴细胞白血病46、C-ALL 普通型急性淋巴细胞白血病47、LSL 淋巴肉瘤白血病48、MH 恶性组织细胞病49、MDS骨髓增生异常综合症50、MPD 慢性骨髓增殖性疾病51、MF 骨髓纤维化52、MM 多发性骨髓瘤53、ML 恶性淋巴瘤54、HD 霍奇金病55、NHL 非霍奇金淋巴瘤56、Chl 绿色瘤57、HX 组织细胞增生症X58、L-SD 勒雪病59、HSCD 韩-薛=柯病60、GD 高雪病61、N-PD 尼曼-匹克病62、SHH 海蓝组织细胞增多症63、AP 过敏性紫癜64、SLE 系统性红斑狼疮65、AG 粒细胞减少症66、PV 真性红细胞增多症67、ITP 原发性血小板减少性紫癜68、LR 类白血病反应69、lm 传染性单核细胞增多症70、Hm 脾功能亢进71、DIC 弥漫性血管内凝血72、POX 过氧化物酶染色73、SB(SBB) 苏丹黑B染色74、ALP 碱性磷酸酶染色75、NAP 中性粒细胞碱性磷酸酶染色76、ACP 酸性磷酸酶染色77、NAE 非特异性酯酶染色78、ANAE 酸性非特异性酯酶染色79、CE 特异性酯酶染色80、MPO 髓性过氧化物酶染色81、PPO 血小板过氧化物酶染色82、PAS 过碘酸席夫染色(糖原染色)83、NBT 硝基蓝四氮唑染色84、TaT 末端脱氧核苷酸转移酶85、UHT 尿水解试验作者: 佚名。

缺铁性贫血的缩写【篇一:缺铁性贫血的缩写】【疾病名】缺铁性贫血【英文名】iron deficiency anemia 【缩写】【别名】【icd 号】d50 【概述】缺铁性贫血(iron-deficiency anemia ,ida)是指由于体内贮存铁消耗殆尽、不能满足正常红细胞生成的需要而发生的贫血。
在红细胞的产生受到限制之前,体内的铁贮存已耗尽,此时称为缺铁。
缺铁性贫血的特点是骨髓及其他组织中缺乏可染铁,血清铁蛋白及转铁蛋白饱和度均降低,呈现小细胞低色素性贫血。
【流行病学】缺铁性贫血在生育年龄的妇女和婴幼儿中发病较多。
据who 1985 年报道,全球约30%的人患有贫血,其中至少半数(即约5~6 亿)为缺铁性贫血。
在大多数发展中国家里约有2/3 的儿童和育龄妇女缺铁,其中1/3 为缺铁性贫血。
在发达国家亦有20%的育龄妇女及40%左右的妊娠妇女患缺铁性贫血。
北京协和医院于1986~1990 年对河北、陕西、广东三省1851 岁以下儿童的调查发现缺铁及缺铁性贫血的发生率分别为49.0%和15.3%。
【病因】人体内的铁是呈封闭式循环的。
正常情况下,铁的吸收和排泄保持着动态的平衡,人体一般不会缺铁,只在需要增加、铁的摄入不足及慢性失血等情况下造成长期铁的负平衡才致缺铁。
造成缺铁的病因可分为铁摄入不足和丢失过多两大类(表1)。
1.铁摄入不足最常见的原因是食物中铁的含量不足、偏食或吸收不良。
食物中的血红素铁容易被吸收,且不受食物组成及胃酸的影响。
非血红素铁则需要先变成fe 才能被吸收。
蔬菜、谷类、茶叶中的磷酸盐、植酸、丹宁酸等可影响铁的吸收。
成年人每天铁的需要量约为1~2mg。
男性1mg/d 即够,生育年龄的妇女及生长发育的青少年铁的需要增多,应为1.5~2mg/d。
如膳食中铁含量丰富而体内贮存铁量充足,一般极少会发生缺铁。
造成铁摄入不足的其他原因是药物或胃肠疾患影响了铁的吸收,某些金属如镓、镁的摄入,制酸剂中的碳酸钙和硫酸镁,溃疡病时服用的h 抑制剂等,均可抑制铁的吸收。
萎缩性胃炎、胃及十二指肠手术后胃酸减少影响铁的吸收等,均是造成铁摄入不足的原因。
2.铁丢失过多正常人每天从胃肠道、泌尿道及皮肤上皮细胞中丢失的铁约为1mg。
妇女在月经期、分娩和哺乳时有较多的铁丢失。
临床上铁丢失过多在男性常是由于胃肠道出血,而女性则常是由于月经过多。
胃肠道出血常见原因是由于膈疝、食管静脉曲张、胃炎(药物及毒素引起)、溃疡病、溃疡性结肠炎、痔、动静脉畸形、息肉、憩室炎、肿瘤及钩虫感染。
酗酒、服用阿司匹林及肾上腺皮质激素和非肾上腺皮质激素抗炎药者,以及少见的血管性紫癜、遗传性毛细血管扩张症及维生素c 缺乏症等,也常会有胃肠道的小量慢性失血。
其他系统的出血,见于泌尿系肿瘤、子宫肌瘤、反复发作的阵发性睡眠性血红蛋白尿症和咯血,止血凝血障碍性疾病或服用抗凝剂等。
如补充不足均会导致铁的负平衡。
如多次妊娠则铁的需要量更要增加。
献血员每次献血400ml 约相当于丢失铁200mg。
约8%的男性献血员及23%女性献血员的血清铁蛋白降低。
如在短期内多次献血,情况会加重。
【发病机制】铁是人体必需的微量元素,存在于所有生存的细胞内。
铁除参与血红蛋白合成外,还参加体内的一些生物化学过程,包括线粒体的电子传递、儿茶酚胺代谢及dna 的合成。
已知多种酶需要铁,如过氧化物酶、细胞色素c 还原酶、琥珀酸脱氢酶、核糖核酸还原酶及黄嘌呤氧化酶等蛋白酶及氧化还原酶中都有铁。
如缺乏,将影响细胞的氧化还原功能,造成多方面的功能紊乱。
【临床表现】缺铁性贫血的临床表现是由贫血、缺铁的特殊表现及造成缺铁的基础疾病所组成。
1.症状贫血的发生是隐伏的。
症状进展缓慢,患者常能很好地适应,并能继续从事工作。
贫血的常见症状是头晕、头痛、乏力、易倦、心悸、活动后气短、眼花、耳鸣等。
2.特殊表现缺铁的特殊表现有:口角炎、舌乳突萎缩、舌炎,严重的缺铁可有匙状指甲(反甲),食欲减退、恶心及便秘。
欧洲的患者常有吞咽困难、口角炎和舌异常,称为plummer-vinson 或paterson-kelly 综合征,这种综合征可能与环境及基因有关。
吞咽困难是由于在下咽部和食管交界处有黏膜网形成,偶可围绕管腔形成袖口样的结构,束缚着食管的开口。
常需要手术破除这些网或扩张狭窄,单靠铁剂的补充无济于事。
3.非贫血症状缺铁的非贫血症状表现:儿童生长发育迟缓或行为异常,表现为烦躁、易怒、上课注意力不集中及学习成绩下降。
异食癖是缺铁的特殊表现,也可能是缺铁的原因,其发生的机制不清楚。
患者常控制不住地仅进食一种“食物”,如冰块、黏土、淀粉等。
铁剂治疗后可消失。
4.体征体征除皮肤黏膜苍白、毛发干枯、口唇角化、指甲扁平、失光泽、易碎裂,约18%的患者有反甲,约10%缺铁性贫血患者脾脏轻度肿大,其原因不清楚,患者脾内未发现特殊的病理改变,在缺铁纠正后可消失。
少数严重贫血患者可见视网膜出血及渗出。
【并发症】贫血严重时可并发贫血性心脏病。
【实验室检查】 1.血象呈现典型的小细胞低色素性贫血(mcv<80fl、mch<27pg、mchc< 30%)。
红细胞指数改变的程度与贫血的时间和程度相关。
红细胞宽度分布(rdw) 在缺铁性贫血的诊断中意义很难定,正常为(13.41.2)%,缺铁性贫血为 16.3%(或>14.5%)特殊性仅为50%~70%。
血片中可见红细胞染色浅淡,中心淡染区扩大,大小不一。
网织红细胞大多正常或轻度增多。
白细胞计数正常或轻度减少,分类正常。
血小板计数在有出血者常偏高,在婴儿及儿童中多偏低。
2.骨髓象骨髓检查不一定需要,除非是需要与其他疾患的贫血相鉴别时。
骨髓涂片表现增生活跃,幼红细胞明显增生。
早幼红及中幼红细胞比例增高,染色质颗粒致密,细胞质少,血红蛋白形成差。
粒系和巨核细胞系正常。
铁粒幼细胞极少或消失。
细胞外铁缺如。
(3)红细胞游离原卟啉(fep)测定:fep 增高表示血红素合成有障碍,用它反映缺铁的存在,是较为敏感的方法。
但在非缺铁的情况如铅中毒及铁粒幼细胞贫血时,fep 亦会增高。
应结合临床及其他生化检查考虑。
【其他辅助检查】为明确贫血的病因或原发病,尚需进行:多次大便潜血、尿常规检查,必要时还应进一步查肝肾功能,胃肠x 线检查、胃镜检查及相应的生化、免疫学检查等。
【诊断】仔细询问及分析病史,加上体格检查可以得到诊断缺铁性贫血的线索,确定诊断还须有实验室证实。
临床上将缺铁及缺铁性贫血分为:缺铁、缺铁性红细胞生成及缺铁性贫血3 个阶段。
其诊断标准分别如下:此时仅有体内储存铁的消耗。
符合(1)再加上(2)或(3)中任何一条即可诊断。
(1)有明确的缺铁病因和临床表现。
(3)骨髓铁染色显示铁粒幼细胞<10%或消失,细胞外铁缺如。
2.缺铁性红细胞生成指红细胞摄入铁较正常时为少,但细胞内血红蛋白的减少尚不明显。
符合缺铁的诊断标准,同时有以下任何一条者即可诊断。
(1)转铁蛋白饱和度<15%。
(2)红细胞游离原卟啉>0.9mol/l 或>4.5g/ghb。
3.缺铁性贫血红细胞内血红蛋白减少明显,呈现小细胞低色素性贫血。
诊断依据是:符合缺铁及缺铁性红细胞生成的诊断;小细胞低色素性贫血;铁剂治疗有效。
诊断评析: (1)血清铁测定受许多因素的影响:不能单独成为诊断缺铁的指标,应强调具备血清总铁结合力>64.44mol/l(360g/l),转铁蛋白饱和度<15%,才能诊断为缺铁。
单有血清铁降低,不能诊断为“缺铁”,因为不易与其他铁利用障碍引起的血清铁降低(如慢性病贫血)相鉴别。
同样如总铁结合力< 64.44mol/l(360g/l),转铁蛋白饱和度>15%,不能诊断为“缺铁”。
(2)过去认为骨髓铁染色示骨髓可染铁消失是诊断缺铁的“金标准”:自 20 世纪70 年代采用放免法测定铁蛋白后,很少再用,因为骨髓铁染色法要求制作条件高,且常受不同部位骨髓取材结果不一致的影响,故在临床上血清铁蛋白测定已代替骨髓铁染色法成为诊断缺铁的“金标准”,目前认为血清铁蛋约等于100mg的铁贮存量。
(3)临床上不少缺铁性贫血患者常与各种慢性疾病(包括炎症、肿瘤和感染) 合并存在:血清铁蛋白水平受慢性疾病的影响会有增高。
对慢性疾病患者伴缺铁时血清铁蛋白的标准尚未统一(有的文献认为应大于60~140g/l)。
对这类患者除仔细分析临床和实验室检查结果外,最好进一步测转铁蛋白受体(缺铁时应该增加)或红细胞铁蛋白(<5g/ml 细胞为缺铁)。
【鉴别诊断】主要与其他小细胞低色素性贫血相鉴别。
1.珠蛋白生成障碍性贫血(地中海贫血) 常有家族史,血片中可见多数靶形红细胞,血红蛋白电泳中可见胎儿血红蛋白(hbf)或血红蛋白a2(hba2)增加。
患者的血清铁及转铁蛋白饱和度、骨髓可染铁均增多。
2.慢性病贫血血清铁虽然降低,但总铁结合力不会增加或有降低,故转铁蛋白饱和度正常或稍增加。
血清铁蛋白常有增高。
骨髓中铁粒幼细胞数量减少,巨噬细胞内铁粒及含铁血黄素颗粒明显增多。
3.铁粒幼细胞性贫血临床上不多见。
好发于老年人。
主要是由于铁利用障碍。
常为小细胞正色素性贫血。
血清铁增高而总铁结合力正常,故转铁蛋白饱和度增高。
骨髓中铁颗粒及铁粒幼细胞明显增多,可见到多数环状铁粒幼细胞。
血清铁蛋白的水平也增高。
【治疗】 1.病因治疗应尽可能地去除导致缺铁的病因。
单纯的铁剂补充只能使血象恢复。
如对原发病忽视,不能使贫血得到彻底的治疗。
2.铁剂的补充铁剂的补充治疗以口服为宜,每天元素铁150~200mg 可。
常用的是亚铁制剂(琥珀酸亚铁或富马酸亚铁)。
于进餐时或餐后服用,以减少药物对胃肠道的刺激。
铁剂忌与茶同服,否则易与茶叶中的鞣酸结合成不溶解的沉淀,不易被吸收。
钙盐及镁盐亦可抑制铁的吸收,应避免同时服用。
患者服铁剂后,自觉症状可以很快地恢复。
网织红细胞一般于服后3~4 天上天左右达高峰。
血红蛋白于2周后明显上升,1~2 个月后达正常水平。
在血红蛋白恢复正常后,铁剂治疗仍需继续服用,待血清铁蛋白恢复到50g/l 再停药。
如果无法用血清铁蛋白监测,则应在血红蛋白恢复正常后,继续服用个月,以补充体内应有的贮存铁量。
如果患者对口服铁剂不能耐受,不能吸收或失血速度快须及时补充者,可改用胃肠外给药。
常用的是右旋醣酐铁或山梨醇铁肌内注射。
治疗总剂量的计算方法是:所需补充铁(mg)=(150-患者hb g/l)3.4(按每1000ghb 3.4g)体重(kg)0.065(正常人每kg体重的血量约为65m1)1.5(包括补充储存铁)。
上述公式可简化为:所需补充铁(mg)=(150-患者hb g/l)体重 (kg)0.33。
首次给注射量应为50mg,如无不良反应,第2 次可增加到 100mg,以后每周注射2~3 次,直到总剂量用完。
约有5%~13%的患者于注射铁剂后可发生局部肌肉疼痛、淋巴结炎、头痛、头晕、发热、荨麻疹及关节痛等,多为轻度及暂时的。